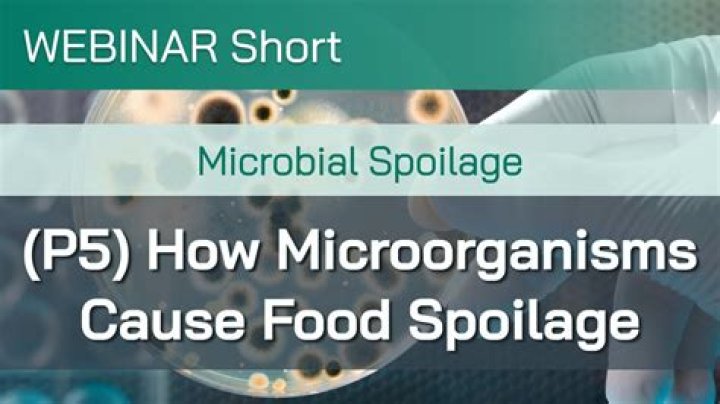

spoilage organisms, check these out | What is an example of spoilage microorganism?
Spoilage bacteria are microorganisms too small to be seen without a microscope that cause food to deteriorate and develop unpleasant odors, tastes, and textures. These one-celled microorganisms can cause fruits and vegetables to get mushy or slimy, or meat to develop a bad odor.
What is an example of spoilage microorganism?
The predominant bacteria associated with spoilage are Brochothrix thermosphacta, Carnobacterium spp., Lactobacillus spp., Lactococcus spp., Leuconostoc spp., Pediococcus spp., Stretococcus spp., Kurthia zopfii, and Weisella spp.
What organisms cause food spoilage?
Organisms that cause food spoilage–molds, yeasts and bacteria–are present everywhere in the air, soil and water. Enzymes that may cause undesirable changes in flavor, color and texture are present in raw vegetables.
Is spoilage a microorganism?
Spoilage microorganisms grow and produce different molecules that are involved in off-odor and off-flavor of foods. The spoilage depends on the microorganisms’ ability to adapt to the food ecosystem conditions and to metabolize the matrix.
What is spoilage in microbiology?
• MICROBIAL SPOILAGE: This refers to damage to food, pharmaceutical products that is caused by micro organisms (bacteria, moulds and yeasts). Micro organisms can grow in almost all kinds of food products. As micro-organisms occur everywhere around us, there is always a risk of microbial spoilage.
Is E coli a spoilage organism?
Although some people may become physically ill due to smells or disgusting flavors, food spoilage organisms don’t cause life-threatening infections. coli, noro virus, and giardia, but there are about 200 known food-borne pathogens in the world.
What are the types of spoilage?
8.5 Food spoilage
1 Microbial spoilage. Microbial spoilage is caused by microorganisms like fungi (moulds, yeasts) and bacteria. 2 Physical spoilage. Physical spoilage is due to physical damage to food during harvesting, processing or distribution. 3 Chemical spoilage. 4 Appearance of spoiled food.
What causes spoilage?
Various factors cause food spoilage, making items unsuitable for consumption. Light, oxygen, heat, humidity, temperature and spoilage bacteria can all affect both safety and quality of perishable foods. Microbial spoilage results from bacteria, molds, and yeast.
What is an example of food spoilage?
Food spoilage occurs when there’s a disagreeable change in the normal state of the food. This may be a change to the smell, taste, touch or sight of the food. Spoilage is usually caused by bacteria, moulds or yeasts. A typical example of spoilage is green fuzzy patches appearing on a piece of bread.
What is the meaning of the spoilage?
Definition of spoilage
1 : the act or process of spoiling especially : the process of decay in foodstuffs. 2 : something spoiled or wasted.
Can you see spoilage bacteria?
Spoilage bacteria are microorganisms too small to be seen without a microscope that cause food to deteriorate and develop unpleasant odors, tastes, and textures. These one-celled microorganisms can cause fruits and vegetables to get mushy or slimy, or meat to develop a bad odor.
What is another word for spoilage?
In this page you can discover 18 synonyms, antonyms, idiomatic expressions, and related words for spoilage, like: waste, decomposition, rot, rottenness, deterioration, putridness, breakdown, spoiling, contamination, spoil and better.
What is physical spoilage?
Physical spoilage is due to physical damage to food during harvesting, processing or distribution. The damage increases the chance of chemical or microbial spoilage and contamination because the protective outer layer of the food is bruised or broken and microorganisms can enter the foodstuff more easily.
What is normal spoilage?
Normal spoilage refers to the inherent worsening of products during the production or inventory processes of the sales cycle. This is the deterioration of a firm’s product line that is generally considered to be unavoidable and expected.
What is the difference between spoilage and deterioration?
In simple terms food deterioration can be referred to as food spoilage. When a food undergoes some unwanted chemical changes which makes the food unhealthy for human consumption it is termed as spoiled food or deteriorated food and the process is called food deterioration.
What is non microbial spoilage?
According to the cause of the spoilage, types of food spoilage fall into two major categories. Microbial spoilage is caused by microorganisms and their products; non-microbial spoilage can be caused by foreign material in the foodstuff or by enzymes that occur in the foodstuff naturally [6].
Can viruses spoil food?
How do viruses get into food? Contrary to bacteria, viruses cannot multiply in food; they are only able to get into food by external contamination. One can differentiate between two sources of contamination: Primary contamination results from contaminated raw materials.
Which bacteria causes illness and spoilage of food?
The top five germs that cause illnesses from food eaten in the United States are:
Norovirus.Salmonella.Clostridium perfringens.Campylobacter.Staphylococcus aureus (Staph)
Why is food spoilage bad?
Spoiled food consumption is dangerous because it often contains mycotoxins and microbial wastes. Because of this, visibly spoiled food is often destroyed and non-visibly spoiled food with a passed due date will be destroyed as well.
Related Archive

harry potter wizards unite wand guide, latest free online harry potter movies, best HD videos you should watch in 2022 – 2023

harry potter villain test, latest free online harry potter movies, best HD videos you should watch in 2022 – 2023

harry potter uk edition books, latest free online harry potter movies, best HD videos you should watch in 2022 – 2023
